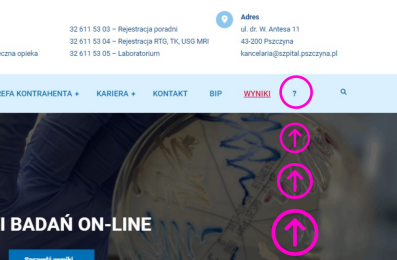

STRONA GŁÓWNA
-

Dyrektor Szpitala o remoncie parteru: Działamy dla naszych pacjentów
-

BRAKUJE INFORMACJI NA STRONIE SZPITALA? ZGŁOŚ NAM TO!
-

Jak pracuje Izba przyjęć
-

5 LAT DZIAŁALNOŚCI PSZCZYŃSKIEGO SZPITALA
-

Od 2 SIERPNIA ZMIANA LOKALIZACJI NOCNEJ I ŚWIĄTECZNEJ OPIEKI ZDROWOTNEJ
-

INFORMACJA W SPRAWIE FUNKCJONOWANIA SZPITALA